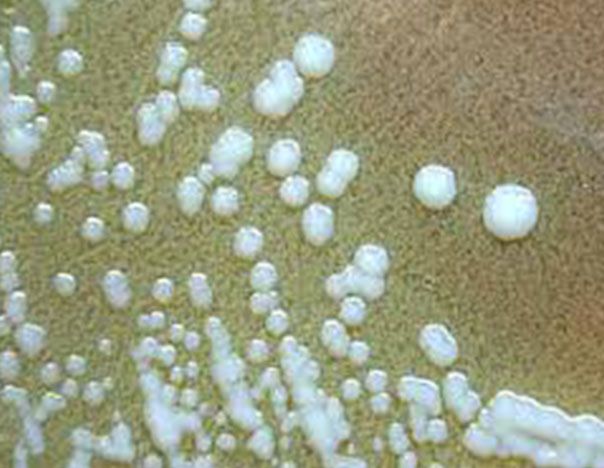

La ciencia detrás de las armas biológicas (V)
FOTO: Internet
La demencia de Atenea
Por Mario Jaime
La Paz, Baja California Sur (BCS). En los años posteriores a la Segunda Guerra Mundial los periódicos reportaban varios incidentes atribuidos a la guerra biológica. En 1947 se dispersó el cólera en Egipto y se acusó a agentes sionistas infiltrados. En 1950, el gobierno de Alemania Oriental acusó a los Estados Unidos de lanzar escarabajos de Colorado sobre su país mientras que en 1951, una gaceta de la marina soviética reportó que los Estados Unidos probaban agentes biológicos en los esquimales de Canadá, lo que había causado una plaga en 1949.
En el escenario de la Guerra de Corea en 1952, China admitió que de sus más de 11 mil prisioneros de guerra, 3 198 eran estadounidenses. Entonces el público se conmocionó cuando se filtró a la prensa que algunos prisioneros confesaron que los Estados Unidos usaba armas biológicas contra los norcoreanos. Esta información surgió cuando dos pilotos capturados por los chinos, John Quinn y Kenneth Enoch, declararon que su misión consistía en lanzar bombas con tifoidea, bacterias de cólera y esporas de carbunclo. A partir de esta información la Unión Soviética acusó al gobierno estadounidense de crímenes de guerra. Para confirmar el hecho, el coronel Frank H. Schwable, que llevaba un año siendo torturado en los campos de Manchuria, proporcionó a los comunistas una detallada descripción del programa de las armas biológicas. Otros 35 prisioneros confesaron lo mismo. Sin embargo, el uso de armas biológicas por parte del ejército de la ONU en contra de los norcoreanos era falso. Los chinos, para desacreditar a sus enemigos y como medio de propaganda, obligaron por medio de torturas a los prisioneros a divulgar el rumor. La Cruz Roja Internacional quiso realizar una investigación al respecto pero los chinos se negaron.
También te podría interesar: La ciencia detrás de las armas biológicas (IV)
Si creemos a las acusaciones de todos los bandos podemos pensar que los británicos usaron agentes biológicos en Omán en 1957, cuando se enfrentaron las fuerzas del imanato contra las del sultanato en la Guerra de Jebel Akhdar. En 1966, los egipcios acusaron que “agresores imperialistas” habían diseminado el cólera en Irak. En 1970, latifundistas brasileños infectaron deliberadamente a tribus amazónicas para despojarlos de sus tierras.
Durante la Guerra de Vietnam, el Vietcong usó los palos pungi, lanzas contaminadas con materia fecal como trampas enterradas en la jungla para infectar a los soldados estadounidenses.

En el marco de este conflicto y sus remantes, algunos helicópteros soviéticos rociaron a los habitantes de Laos y Kampuchea con aerosoles de colores. Los animales y los humanos que lo absorbieron se sentían desorientados y enfermos. Algunos sufrieron una disminución aguda de los granulocitos sanguíneos llamada neutropenia, sangraron de la nariz, las mujeres de la vagina y murieron entre diarreas y dolores espantosos. Se conoció a esta arma como lluvia amarilla. Diversos científicos lanzaron la hipótesis de que esta arma se parecía a los excrementos de abeja que resultan tóxicos.
Se supo después que los aerosoles llevaban la micotoxina Tricoteceno 2 (T-2), una sustancia producida por hongos. La familia de los tricocenos es sintetizada principalmente por hongos Fusarium, fitopatógenos que dañan los cultivos.
Los rusos empezaron a investigar la T-2 en sus laboratorios de guerra biológica de Taskent en Uzbekistán cuando descubrieron que era el principio activo del hongo lo que dañó toneladas de trigo en los años 40’s y tenía una letalidad del 60%. Durante los conflictos de Vietnam y después en Afganistán, de 1975 a 1981 causaron más de 6 mil muertes debido a la lluvia amarilla.
En los 50’s, el programa de armas biológicas en los Estados Unidos se llevó a cabo en los laboratorios de Fort Detrick; era ultra secreto y hasta la fecha no se han desclasificado muchos documentos relativos a él. Se sabe que en 1953, el mayor Bullene, jefe de la Oficina Química, resaltó la investigación del ántrax como prioridad suprema.
En 1954 hubo una epidemia de fiebre amarilla en Trinidad. Los científicos estadounidenses de Fort Detrick aislaron un flavivirus de un hombre infectado durante la epidemia y lo inocularon en macacos Rhesus en pos de propagar la enfermedad. Realizaron un experimento liberando mosquitos no infectados en Savannah, Georgia y Avon Park, Florida, por medio de aviones y helicópteros. En un solo día, los mosquitos se dispersaron varias millas cuadradas y picaron a muchas personas, lo que consolidó la viabilidad de un ataque eficaz. En Fort Detrick se produjeron 500 mil mosquitos por mes con la idea de lograr 130 millones al mes, cosa que no se logró por las limitaciones del proyecto.
Los flavivirus con toda una familia de virus de RNA que no solo provocan fiebre amarilla sino dengue y zika, enfermedades transmitidas principalmente por mosquitos de los géneros Haemagogus y Aedes. Estos males tienen en común varios síntomas como fiebre, cefaleas, ictericia, dolores musculares, náuseas, vómitos y cansancio.
La primera arma biológica estandarizada fue la bomba antipersonal M114 4-lb que contenía 320 mL de Brucella suis en un tubito de 5.3 cm de largo. Se colocaban 108 de estos tubitos en una bomba más grande nombrada M33 500-lb.
a) Bomba antipersonal M114 4-lb. b) Bomba M33 500-lb
Estas bombas se probaron en Dugway Proving Ground, Utah, con el objetivo de diseminar la brucelosis.
Luego se estandarizó la bomba M115 500-lb para diseminar la roya negra, el hongo Puccinia graminis. Este infecta al trigo mediante una enfermedad conocida como niebla de los cereales (en México se conoce como el Chahuixtle negro) y puede socavarlo de tal forma que se pierda la cosecha total. La estrategia de propagar la roya consiste en matar de hambre a una población que dependa del trigo.

Otros sistemas de propagación de bacterias, hongos y virus son tanques de spray, misiles, aerosoles, minas submarinas y drones. Las minas subacuáticas con especialmente furtivas pues se diseñaron para ser disparadas a través de un tubo de torpedo, permanecer dos horas en el fondo, emerger de súbito y liberar 42 L del agente biológico, después de lo cual se autodestruye.
En la década de los 60’s el programa de armas biológicas de los EU estaba en declive. Sólo recibió $ 38 millones de dólares en 1966 y $ 31 millones en 1969. Sin embargo, se logró estandarizar una bomba de Pasteurella tularensis (nombrada actualmente Francisella tularensis) bacteria causante de la tularemia o fiebre de los conejos. La bacteria infecta mosquitos, tábanos garrapatas y a la mayoría de los mamíferos, especialmente roedores y ovejas. Puede sobrevivir meses en el agua y en la vegetación y en el hombre causa fiebre intensa, escalofríos, náuseas, cefaleas, dolores articulares, inflamación de nódulos, pus, tos seca, diarrea y hasta neumonía.
Cuando los alemanes sitiaron Stalingrado en 1945, los casos de tularemia entre los alemanes llegaron a más de cien mil, aunque la infección también se propagó entre los rusos. Según el coronel Kanatzhan «Kanat» Alibekov, microbiólogo que logró estandarizar una bomba de tularemia en los 70’s, la epidemia de la Segunda Guerra Mundial fue producida por un arma biológica soviética lo que nunca se ha podido probar.
Continuará…
Referencias
Kamieński, L. (2017). Las drogas en la guerra: una historia global. Barcelona: Crítica.
Robinson J, Guillemin J, Meselson M. Yellow rain: The story collapses. (1987) Foreign Policy.68:101–117.
Smart, J. K. (1997). History of chemical and biological warfare: an American perspective. Medical Aspects of Chemical and Biological Warfare. Washington, DC: Office of the Surgeon General, 9-86.
Smart J. K. (1996) Biological Weapons. Aberdeen Proving Ground, Md:
US Army Chemical and Biological Defense Command. (1996) Special Study 55. Not cleared for public release.
US Army Chemical Corps. Summary of Major Events and Problems, FY58. (1959) Army Chemical Center, Md: US Army Chemical Center Historical Center; Mar 1959.
__
AVISO: CULCO BCS no se hace responsable de las opiniones de los colaboradores, esto es responsabilidad de cada autor; confiamos en sus argumentos y el tratamiento de la información, sin embargo, no necesariamente coinciden con los puntos de vista de esta revista digital.








